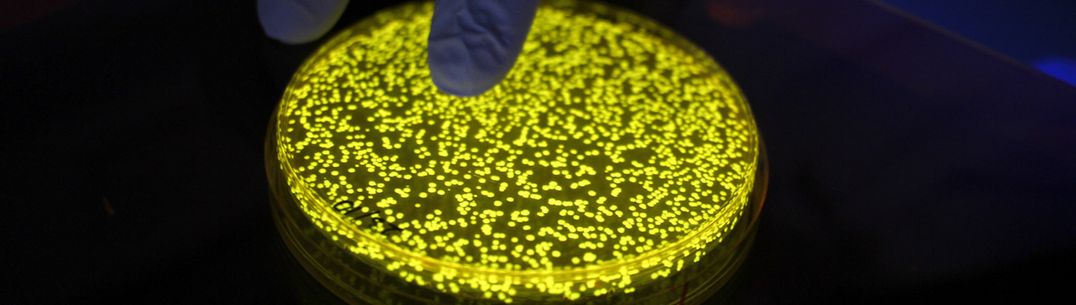

Biotechnology and engineering
Our Biotechnology and engineering division of the Fungal Science Network encompasses areas including synthetic genome editing, vaccine development, as well as microfluidic technology development. Within the Department of Bioengineering, Tom Ellis and Rodrigo Ledesma Amaro are focussed on synthetic genome engineering, metabolism and biomaterials in model yeast, and Claire Stanley is developing novel microfluidic “organ-on-a-chip" technologies to image various interactions between fungi, bacteria and plants at the single cell level. There is a further focus on the imaging of fungal interactions with the host in the Life Sciences (Michalis Barkoulas, Tolga Bozkurt) and Infectious Disease (Darius Armstrong-James).
Matt Fisher and Anand Shah in Public Health and Pietro Spanu in Life Sciences have a strong focus on genomics in plant, animal and human pathogens, and Darius Armstrong-James, Jesus Rodriguez Manzano and Matt Fisher are developing a range of nucleic-acid sensing-based diagnostics for human fungal infections. Sanjay Chotirmal, Anand Shah and Darius Armstrong-James are developing further antibody-based diagnostic assays for human fungal diseases.
Darius Armstrong-James, Matt Fisher, Anna Reed and Kaz Ito are heavily involved in the development of human inhaled antifungals now commencing Phase 3 clinical studies through the Imperial spin-out company Pulmocide, where further therapeutic avenues include vaccines (Ernesto Cota) and chimeric-antigen receptor-based engineered cellular therapies (Sanjay Chotirmal, Darius Armstrong-James). Other areas of strength include metagenomics, where Matt Fisher, Sanjay Chotirmal, and Bill Cookson have a strong focus, and metabolomics, with Darius Armstrong-James leading the high-throughput phenotypic microarray facility.